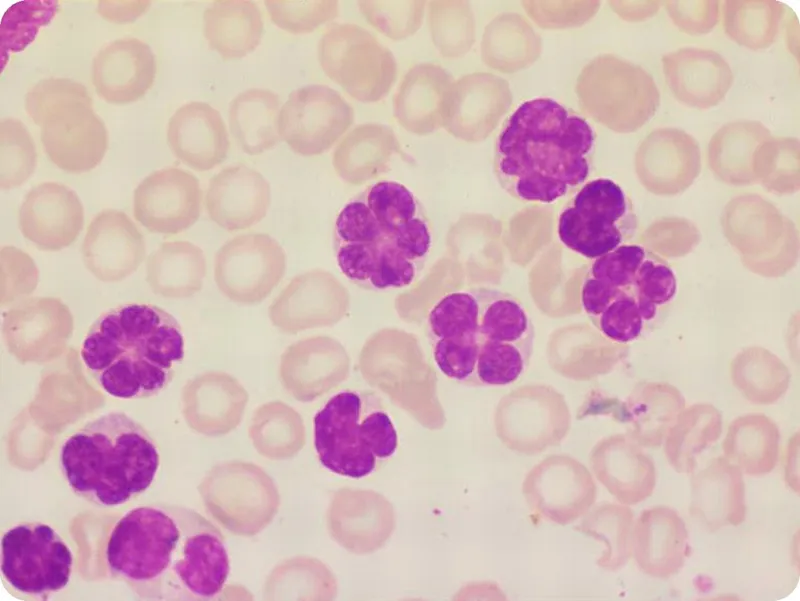
Peripheral blood smear: Adult T-cell Leukemia/Lymphoma

HTLV-1 Basics - The Retro Renegade
- Family: Retroviridae; a single-stranded RNA virus.
- Transmission: Primarily vertical (breastfeeding), sexual contact, and parenteral routes (IV drug use, blood transfusions).
- Key Oncogene: The viral tax gene.
- Its protein product, Tax, is a potent trans-activator of cellular genes.
- Drives T-cell proliferation by upregulating IL-2 and its receptor (IL-2R).
- Inactivates tumor suppressors like p53.
- Hallmark: Very long latency period (20-30 years).
⭐ The vast majority of infected individuals are asymptomatic carriers, creating a silent reservoir for transmission.

Oncogenesis - Malignant Transformation
- Primary Mechanism: Viral proteins, primarily Tax and HBZ, drive malignant transformation of CD4+ T-cells.
- Tax Protein: Acts as a potent oncoprotein.
- Transactivates viral genes and host genes promoting cell growth (e.g., IL-2, IL-2R) via the NF-κB pathway.
- Inhibits tumor suppressors like p53 and cell cycle regulators.
- HBZ Protein: Promotes T-cell proliferation and is essential for viral persistence.
⭐ The hallmark of HTLV-1 oncogenesis is the pleiotropic action of the Tax protein, which simultaneously promotes uncontrolled cell division and disables the cell's safety mechanisms (tumor suppressors).

Clinical Syndromes - The Disease Spectrum
-
Adult T-cell Leukemia/Lymphoma (ATLL)
- Aggressive malignancy of mature CD4+ T-cells; long latency (20-30 years).
- Presents with generalized lymphadenopathy, hepatosplenomegaly, lytic bone lesions (leading to hypercalcemia), and characteristic skin lesions (nodules, plaques).
- Peripheral smear shows pathognomonic "flower cells" (multilobulated nuclei).
-
HTLV-1-Associated Myelopathy/Tropical Spastic Paraparesis (HAM/TSP)
- Chronic, progressive demyelinating disease of the spinal cord.
- Insidious onset of symmetric leg weakness, spasticity, back pain, and urinary incontinence.
-
Other Manifestations
- Uveitis, infective dermatitis, Sjögren's syndrome, arthropathy.
⭐ ATLL-induced hypercalcemia is driven by parathyroid hormone-related protein (PTHrP) production by tumor cells, a key mechanism to recall.
Diagnosis - Nailing the Culprit
- Screening & Confirmation:
- Initial screening with ELISA for anti-HTLV-1 antibodies.
- Confirm positive results with a Western blot.
- Direct Virus Detection:
- PCR to detect proviral DNA in host cells is the gold standard for diagnosis.
- Disease-Specific Labs:
- ATL: Peripheral blood smear shows pathognomonic "flower cells" (atypical lymphocytes).
- HAM/TSP: CSF shows lymphocytic pleocytosis & anti-HTLV-1 antibodies.

⭐ The presence of "flower cells" (malignant T-cells with multi-lobulated nuclei) on a blood smear is a classic board question clue for Adult T-cell Leukemia/Lymphoma (ATL).
Management & Prevention - Damage Control
- No cure; management is supportive & disease-specific.
- Adult T-cell Leukemia/Lymphoma (ATL): Combination chemotherapy, antivirals (Zidovudine + IFN-α), and potentially allogeneic stem cell transplant. Prognosis remains poor.
- HAM/TSP: Corticosteroids and immunosuppressants to manage symptoms.
- Prevention is key:
- Screening blood donors.
- Promoting safe sex.
- Advising infected mothers against breastfeeding.
⭐ The viral Tax protein is the primary driver of oncogenesis, dysregulating cell cycle control (e.g., p53) and promoting T-cell proliferation.

High‑Yield Points - ⚡ Biggest Takeaways
- HTLV-1 is an RNA retrovirus that infects CD4+ T-cells.
- Strongly associated with Adult T-cell Leukemia/Lymphoma (ATLL), often presenting with lytic bone lesions and hypercalcemia.
- Also causes HTLV-1-Associated Myelopathy/Tropical Spastic Paraparesis (HAM/TSP), a demyelinating CNS disease.
- Primary transmission routes are vertical (breastfeeding), sexual contact, and parenteral (IV drug use).
- Peripheral blood smear classically shows multi-lobulated lymphocytes called "flower cells".
- Diagnosis is made via serology (ELISA) and confirmed with Western blot or PCR.
Unlock the full lesson and continue reading
Signup to continue reading this lesson and unlimited access questions, flashcards, AI notes, and more